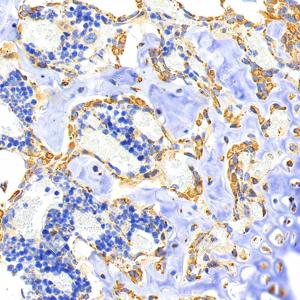

Anti-RANKL Rabbit pAb
- 100 μL
产品信息
|
蛋白质全称 |
肿瘤坏死因子配体超家族成员11 |
|
别名 |
CD254, hRANKL2, ODF, OPGL, OPTB2, Osteoprotegerin ligand, RANKL, sOdf, TNFSF11, TRANCE, Opgl, Rankl, Trance |
|
Uniprot ID |
O35235 |
|
免疫原 |
对应于小鼠RANKL的重组蛋白 |
|
抗体亚型 |
IgG |
|
纯化方式 |
亲和纯化 |
|
亚细胞定位 |
细胞膜, 细胞质, 分泌型 |
应用
| 应用 | 物种 | 稀释 | 阳性样品 |
| IHC/IF 免疫组织化学/免疫荧光 | 小鼠, 大鼠 | 1: 600-1: 2400 | 骨, 脾 |
背景
Cytokine that binds to TNFRSF11B/OPG and to TNFRSF11A/RANK. Osteoclast differentiation and activation factor.Augments the ability of dendritic cells to stimulate naive T-cell proliferation. May be an important regulator of interactions between T-cells and dendritic cells and may play a role in the regulation of the T-cell-dependent immune response. May also play an important role in enhanced bone-resorption in humoral hypercalcemia of malignancy.Induces osteoclastogenesis by activating multiple signaling pathways in osteoclast precursor cells, chief among which is induction of long lasting oscillations in the intracellular concentration of Ca 2+ resulting in the activation of NFATC1, which translocates to the nucleus and induces osteoclast-specific gene transcription to allow differentiation of osteoclasts.During osteoclast differentiation, in a TMEM64 and ATP2A2-dependent manner induces activation of CREB1 and mitochondrial ROS generation necessary for proper osteoclast generation.
图像
|
|
IHC检测RANKL蛋白(货号 GB115705). 样品: 小鼠骨, 4%多聚甲醛 (货号G1101) 固定12-24小时. 抗原修复: 柠檬酸抗原修复液(干粉, pH 6.0) (G1201), 高压锅均匀喷气计时2分钟. —抗: 1: 1000稀释, 4℃ 孵育过夜. 二抗: S-vision免疫组化多聚二抗(山羊抗兔),即用型 (货号G1302), 室温孵育20分钟. |
|
|
IHC检测RANKL蛋白(货号 GB115705). 样品: 小鼠骨, 4%多聚甲醛 (货号G1101) 固定12-24小时. 抗原修复: 柠檬酸抗原修复液(干粉, pH 6.0) (G1201), 高压锅均匀喷气计时2分钟. —抗: 1: 1000稀释, 4℃ 孵育过夜. 二抗: S-vision免疫组化多聚二抗(山羊抗兔),即用型 (货号G1302), 室温孵育20分钟. |
|
|
IHC检测RANKL蛋白(货号 GB115705). 样品: 小鼠脾, 4%多聚甲醛 (货号G1101) 固定12-24小时. 抗原修复: 柠檬酸抗原修复液(干粉, pH 6.0) (G1201), 高压锅均匀喷气计时2分钟. —抗: 1: 1000稀释, 4℃ 孵育过夜. 二抗: S-vision免疫组化多聚二抗(山羊抗兔),即用型 (货号G1302), 室温孵育20分钟. |
|
|
IHC检测RANKL蛋白(货号 GB115705). 样品: 大鼠骨, 4%多聚甲醛 (货号G1101) 固定12-24小时. 抗原修复: 柠檬酸抗原修复液(干粉, pH 6.0) (G1201), 高压锅均匀喷气计时2分钟. —抗: 1: 1000稀释, 4℃ 孵育过夜. 二抗: S-vision免疫组化多聚二抗(山羊抗兔),即用型 (货号G1302), 室温孵育20分钟. |
|
|
IHC检测RANKL蛋白(货号 GB115705). 样品: 大鼠骨, 4%多聚甲醛 (货号G1101) 固定12-24小时. 抗原修复: 柠檬酸抗原修复液(干粉, pH 6.0) (G1201), 高压锅均匀喷气计时2分钟. —抗: 1: 1000稀释, 4℃ 孵育过夜. 二抗: S-vision免疫组化多聚二抗(山羊抗兔),即用型 (货号G1302), 室温孵育20分钟. |
|
|
IHC检测RANKL蛋白(货号 GB115705). 样品: 大鼠脾, 4%多聚甲醛 (货号G1101) 固定12-24小时. 抗原修复: 柠檬酸抗原修复液(干粉, pH 6.0) (G1201), 高压锅均匀喷气计时2分钟. —抗: 1: 1000稀释, 4℃ 孵育过夜. 二抗: S-vision免疫组化多聚二抗(山羊抗兔),即用型 (货号G1302), 室温孵育20分钟. |
储存
| 储存条件 | 在-20℃下储存一年, 避免反复冻融. |
| 储存缓冲液 | 含0.15% ProClin300防腐剂, 100 μg/mL牛血清白蛋白和50%甘油的磷酸盐缓冲液. |
注意:
1.本产品仅供研究使用.
2.建议用一抗稀释液(G2025)稀释本产品.
| 货号 | 名称 | 规格 | 价格 | 操作 |
|---|
| 货号 | 名称 | 规格 | 价格 | 操作 |
|---|